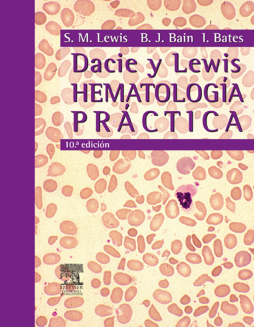

BOOK
Dacie and Lewis. Hematología práctica
S. Mitchell Lewis | Imelda Bates | Barbara J. Bain
(2007)
Additional Information
Book Details
Abstract
- Obra reconocida mundialmente como la 'biblia' de la hematología, que se presenta en forma de manual y que en su 10.ª edición es la obra de referencia por excelencia en el campo del Laboratorio de Hematología. La obra recoge todas las técnicas utilizadas para la investigación de los desórdenes tanto en el sistema hematopoyético como hemostático.
- Se trata de una obra bien organizada, con capítulos dedicados a todas las áreas que se pueden encontrar en un laboratorio de Hematología: hematimetría, citología hematológica, hemostasia, estudio de anemias, inmunofenotipado, citogenética, biología molecular y banco de sangre.
- Cada capítulo está estructurado en apartados y posee un índice al inicio que resulta de mucha utilidad para conocer de antemano todo el contenido del mismo. La exposición de los conceptos es clara y concisa, presentando también un importante número de esquemas muy válidos e ilustraciones de calidad óptima. Igualmente, cada capítulo posee un buen número de citas bibliográficas con una correcta actualización.
- En el libro también se hace una reseña de las webs más importantes relacionadas con Hematología, incluyendo también las vinculadas a los dispositivos o kits de reactivos utilizados.
- Esta 10.ª edición es la obra de referencia por excelencia en el campo del Laboratorio de Hematología.
- Recoge todas las técnicas utilizadas para la investigación de los desórdenes, tanto en el sistema hematopoyético como hemostático.
- Perfectamente estructurada y organizada, incluye una reseña de las webs más importantes relacionadas con la Hematología.